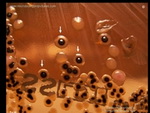
Microbiology tests

PRODUCTS
.JPG) CampMedicaGroup develops and manufactures rapid tests for in vitro diagnostic.
CampMedicaGroup develops and manufactures rapid tests for in vitro diagnostic.Our products brands "SeeNow" & "Trust Me" includes Pregnancy & Fertility tests, Infectious Diseases tests, Sexually Transmitted Diseases tests, Tumor & Cardiac Markers, Drugs of Abuse tests, Microbiology and Parasitology tests. Under "SeeNow" brand we have developed also tests for clinical chemistry, urine reagents strips and
| CODE | PRODUCT / Format | Full Name | Specimen | Remarks | |
| 1. | Rapid tests for Pregnancy & Fertility&Menopause | ||||
| SN1.1 | hCG strip | Human Chorionic Gonadotropin | urine | CE compliant to Annex III of European Directive 98/79/EC. | |
| SN1.2 | hCG cassette | Human Chorionic Gonadotropin | urine | CE compliant to Annex III of European Directive 98/79/EC. | |
| SN1.1’ | hCG combo strip | Human Chorionic Gonadotropin | Serum / urine | CE compliant to Annex III of European Directive 98/79/EC. | |
| SN1.2’ | hCG combo cassette | Human Chorionic Gonadotropin | Serum / urine | CE compliant to Annex III of European Directive 98/79/EC. | |
| SN1.3 | LH strip | Luteinizing Hormone | urine | CE compliant to Annex III of European Directive 98/79/EC. | |
| SN1.4 | LH cassette | Luteinizing Hormone | urine | CE compliant to Annex III of European Directive 98/79/EC. | |
| SN1.5 | FSH strip | Follicle Stimulating Hormone | urine | CE compliant to Annex III of European Directive 98/79/EC. | |
| SN1.6 | FSH cassette | Follicle Stimulating Hormone | urine | CE compliant to Annex III of European Directive 98/79/EC. | |
| 2. | Rapid tests for Infectious diseases | ||||
| SN2.2 | H. Pylori Ab. cassette | Helicobacter Pylori Antibody | Whole blood/serum/plasma | CE compliant to Annex III of European Directive 98/79/EC. | |
| SN2.2' | H. Pylori Ag. cassette | Helicobacter Pylori Antigen | Feces | CE compliant to Annex III of European Directive 98/79/EC | |
| SN2.3 | Anti-HIV 1,2 cassette | Human Immunodeficiency Virus 1/2 Antibody | Whole blood/serum/plasma | Manufacturer EC Declaration | |
| SN 2.4 | Adenovirus antigen | ... | ... | Manufacturer EC Declaration | |
| SN 2.5 | Rotavirus antigen | ... | ... | Manufacturer EC Declaration | |
| SN 2.6 | Combo Adeno+Rotavirus Ag. | ... | ... | Manufacturer EC Declaration | |
| 3. | Tumor Markers rapid tests | ||||
| SN3.1 | AFP strip | Alpha Fetoprotein | Serum / plasma | CE compliant to Annex III of European Directive 98/79/EC. | |
| SN3.2 | AFP cassette | Alpha Fetoprotein | Serum / plasma | CE compliant to Annex III of European Directive 98/79/EC. | |
| SN3.3 | CEA strip | Carcinoma Embryonic Ag. | Serum / plasma | CE compliant to Annex III of European Directive 98/79/EC. | |
| SN3.4 | CEA cassette | Carcinoma Embryonic Ag. | Serum / plasma | CE compliant to Annex III of European Directive 98/79/EC. | |
| SN3.5 | PSA strip | Prostate Specific Antigen | Serum/plasma/Whole blood | Manufacturer EC Declaration | |
| SN3.6 | PSA cassette | Prostate Specific Antigen | Serum/plasma/Whole blood | Manufacturer EC Declaration | |
| SN3.7 | FOB cassette | Fecal Occult Blood | Feces | CE compliant to Annex III of European Directive 98/79/EC. | |
| 4. | Rapid tests for Sexually transmited diseases | ||||
| SN4.1 | Syphilis strip | Treponema Pallidum (TP) | Serum/plasma/Whole blood | CE compliant to Annex III of European Directive 98/79/EC. | |
| SN4.2 | Syphilis cassette | Treponema Pallidum (TP) | Whole blood/serum/plasma | CE compliant to Annex III of European Directive 98/79/EC. | |
| SN4.4 | Gonorrhea cassette | Neisseria Gonorrhoeae | Urogenital secretions | CE compliant to Annex III of European Directive 98/79/EC. | |
| SN4.5 | Chlamydia cassette | Chlamydia antigen | Urogenital secretions | Manufacturer EC Declaration | |
| 5. | Hepatitis rapid tests | ||||
| SN5.1 | HBsAg strip | Hepatitis B Virus surface Antigen | Serum / plasma/ Whole blood | Manufacturer EC Declaration | |
| SN5.2 | HBsAg cassette | Hepatitis B Virus surface Antigen | Serum / plasma/ Whole blood | Manufacturer EC Declaration | |
| SN5.3 | Anti-HCV strip | Hepatitis C Virus Antibody | Serum/plasma/ Whole blood | Manufacturer EC Declaration | |
| SN5.4 | Anti-HCV cassette | Hepatitis C Virus Antibody | Serum/plasma/ Whole blood | Manufacturer EC Declaration | |
| SN5.5 | Anti-HBs strip | Hepatitis B Virus surface Antibody | Serum / plasma/ Whole blood | Manufacturer EC Declaration | |
| SN5.6 | Anti-HBs cassette | Hepatitis B Virus surface Antibody | Serum / plasma/ Whole blood | Manufacturer EC Declaration | |
| SN5.7 | Anti-HBc strip | Hepatitis B Virus core Antibody | Serum / plasma/ Whole blood | Manufacturer EC Declaration | |
| SN5.8 | Anti-HBc cassette | Hepatitis B Virus core Antibody | Serum / plasma/ Whole blood | Manufacturer EC Declaration | |
| SN5.9 | Anti-HBe strip | Hepatitis B Virus envelope Antibody | Serum / plasma/ Whole blood | Manufacturer EC Declaration | |
| SN5.10 | Anti-HBe cassette | Hepatitis B Virus envelope Antidody | Serum / plasma/ Whole blood | Manufacturer EC Declaration | |
| SN5.11 | HBeAg strip | Hepatitis B Virus envelope Antigen | Serum / plasma/ Whole blood | Manufacturer EC Declaration | |
| SN5.12 | HBeAg cassette | Hepatitis B Virus envelope Antigen | Serum / plasma/ Whole blood | Manufacturer EC Declaration | |
| SN5.13 | Anti-HAV IgG/IgM cassette | Hepatitis A Virus IgG/IgM Antibody | Serum / plasma / Whole blood | Manufacturer EC Declaration | |
| SN5.X.3 | 3 tests - infectious panel | 3 tests- infectious panel | Serum / plasma / Whole blood | Manufacturer EC Declaration | |
| 6. | Cardiac Markers rapid tests | ||||
| SN6.1 | Troponin I cassette | Troponin I | Whole blood/serum/plasma | CE compliant to Annex III of European Directive 98/79/EC. | |
| SN6.2 | Myoglobin cassette | Myoglobin | Whole blood/serum/plasma | CE compliant to Annex III of European Directive 98/79/EC. | |
| SN6.3 | CK - MB cassette | Creatin Kinase-MB | Whole blood/serum/plasma | CE compliant to Annex III of European Directive 98/79/EC. | |
| SN6.X.3 | 3 tests panel | cTnI+CKMB+Myo | Whole blood/serum/plasma | CE compliant to Annex III of European Directive 98/79/EC. | |
| 7. | Rapid tests for DOA (Drugs Of Abuse) | ||||
| SN7.1 | AMP strip/cassette | Amphetamine | urine/saliva | CE compliant to Annex III of European Directive 98/79/EC. | |
| SN7.2 | BAR strip/cassette | Barbiturates | urine | CE compliant to Annex III of European Directive 98/79/EC. | |
| SN7.3 | BZO strip/cassette | Benzodiazepine | urine | CE compliant to Annex III of European Directive 98/79/EC. | |
| SN7.4 | COC strip/cassette | Cocaine | urine/saliva | CE compliant to Annex III of European Directive 98/79/EC. | |
| SN7.5 | MDMA strip/cassette | Methylenedioxymethamphetamine | urine/saliva | CE compliant to Annex III of European Directive 98/79/EC. | |
| SN7.6 | MET strip/cassette | Methamphetamine | urine/saliva | CE compliant to Annex III of European Directive 98/79/EC. | |
| SN7.7 | MOR strip/cassette | Morphine | urine | CE compliant to Annex III of European Directive 98/79/EC. | |
| SN7.8 | MTD strip/cassette | Methadone | urine | CE compliant to Annex III of European Directive 98/79/EC. | |
| SN7.9 | OPI strip/cassette | Opiates | urine | CE compliant to Annex III of European Directive 98/79/EC. | |
| SN7.10 | TCA strip/cassette | Tricyclic Antidepressants | urine | CE compliant to Annex III of European Directive 98/79/EC. | |
| SN7.11 | THC strip/cassette | Tetrahydrocannabinol | urine/saliva | CE compliant to Annex III of European Directive 98/79/EC. | |
| SN 7.14 | OXY strip/cassette | Oxycodone | urine/saliva | CE compliant to Annex III of European Directive 98/79/EC. | |
| SN 7.X | Multi DOA panel | Multi Drugs of abuse panels | urine | CE compliant to Annex III of European Directive 98/79/EC. | |
| 8. | Rapid tests for Parasitology | ||||
| SN 8.1 | Malaria cassette | Malaria P.f/Pan antigen | whole blood | CE compliant to Annex III of European Directive 98/79/EC. | |
| SN 8.1' | Malaria pf/pv cassette | Malaria pf/pv - antigen | whole blood | CE compliant to Annex III of European Directive 98/79/EC. | |
| SN 8.2 | Dengue IgG/IgM cassette | Dengue IgG/IgM antibody | whole blood/serum/plasma | CE compliant to Annex III of European Directive 98/79/EC. | |
| SN 8.3 | Dengue NS1 cassette | Dengue NS1 antigen | whole blood/serum/plasma | CE compliant to Annex III of European Directive 98/79/EC. | |
| SN 8.4 | Dengue COMBO | Dengue IgG/IgM Ab. + NS1 Ag. | wholeblood/serum/plasma | CE complaint to Annex III of European Directive 98/79/EC | |
| SN 8.5 | Coronavirus cassette | Coronavirus 2019 (nCoV) Ab. | whole blood/serum/plasma | CE complaint to Annex III of European Directive 98/79/EC | |
| SN 8.6 | Influenza A+B cassette | Influenza A+B antigen | nasopharingeal secretions | CE complaint to Annex III of European Directive 98/79/EC | |
| SN 8.7 | Coronavirus Ag. cassette | Coronavirus -nCoV Ag. | nasopharingeal secretions | CE complaint to Annex III of European Directive 98/79/EC | |
| SN 8.8 | DUO PANEL | Coronavirus Ag & FLU A+B Ag. | nasopharingeal secretions | CE complaint to Annex III of European Directive 98/79/EC | |
| 9. | Microbiology | ||||
| SN 9.1 | Tuberculosis cassette | Tuberculosis | Whole blood / serum / plasma | CE compliant to Annex III of European Directive 98/79/EC. | |
| SN 9.2 | Salmonella (Typhy) cassette | Salmonella (Typhoid fever) -IgG/IgM | Whole blood / serum / plasma | CE compliant to Annex III of European Directive 98/79/EC. | |
| 10. | TORCH | ||||
| SN 10.1 | Rubella IgG/IgM cassette | Rubella IgG/IgM | Whole blood / serum / plasma | CE Manufacturer EC Declaration | |
| SN 10.2 | TOXO IgG/IgM cassette | Toxoplasma IgG/IgM | Whole blood / serum / plasma | CE Manufacturer EC Declaration | |
| SN 10.3 | CMV IgG/IgM cassette | CMV (citomegalovirus) IgG/IgM | Whole blood / serum / plasma | CE Manufacturer EC Declaration | |
| 11. | Bacteriology | ||||
| SN 11.1 | Tetanus WB/S/P cassette | Tetanus WB/S/P - whole blood/serum/plasma | Whole blood / serum / plasma | CE compliant to Annex III of European Directive 98/79/EC. | |
| SN 11.2 | Streptococ A antigen. | ... | ... | CE compliant to Annex III of European Directive 98/79/EC. | |
| 12. | Toxicology | ||||
| SN 12.1 | Alcohol urine / saliva cassette | Alcohol urine / saliva | urine / saliva | CE compliant to Annex III of European Directive 98/79/EC. | |
| 13. | Clinical Chemistry | ||||
| SN 13.1 | Urine strip TEST | Urine strips - 10 parameters | urine | CE compliant to Annex III of European Directive 98/79/EC. | |
| SN 13.2 | Urine strip TEST | Urine strips - 11 parameters | urine | CE compliant to Annex III of European Directive 98/79/EC. | |
| SN 13.3 | Urine strip TEST | Urine strips - 12 parameters | urine | CE compliant to Annex III of European Directive 98/79/EC. | |
| SN 13.4 | Urine strip TEST | Urine strips - 13 parameters | urine | CE compliant to Annex III of European Directive 98/79/EC. | |
 Pregnancy & Fertility & Menopause rapid tests
Pregnancy & Fertility & Menopause rapid tests
IVD for professional use
| Code | Product / format | specimen | package | Shelf life | Sensitivity | Specificity | Inserts |
| SN1.1 | hCG strip | urine | 50 tests/box | 24 months | 20 mIU/mL | >96% | |
| SN1.2 | hCG cassette | urine | 30 tests/box | 24 months | 20 mIU/mL | >96% | |
| SN1.1’ | hCG strip | Urine / serum | 50 tests/box | 24 months | 20 mIU/mL | >96% | |
| SN1.2’ | hCG cassette | Urine / serum | 30 tests/box | 24 months | 20 mIU/mL | >96% | |
| SN1.3 | LH strip | urine | 50 tests/box | 18 months | 30 mIU/mL | 99,5% | |
| SN1.4 | LH cassette | urine | 30 tests/box | 18 months | 30 mIU/mL | 99,5% | |
| SN1.5 | FSH strip | urine | 50 tests/box | 18 months | 25 mIU/mL | >99% | |
| SN1.6 | FSH cassette | urine | 30 tests/box | 18 months | 25 mIU/mL | >99% |
OEM and bulk packaging are available for all products
If you have any questions or wish to order this product please click here
 Infectiuos Diseases rapid tests
Infectiuos Diseases rapid tests
IVD for professional use
| Code | Product / format | specimen | package | Shelf life | Sensitivity | Specificity | Inserts |
| SN2.2 | H.Pylori antibody | Whole blood/serum/plasma | 30 tests/box | 24 months | 98% | 98% | |
| SN2.2' | H.Pylori antigen | Feces | 30 tests/box | 24 months | >94% | 97% | |
| SN2.3 | Anti-HIV 1,2 cassette | Whole blood/serum/plasma | 30 tests/box | 18 months | >99% | 99% | |
| SN 2.4 | Adenovirus antigen | Whole blood/serum/plasma | 30 tests/box | 18 months | >99% | 99% | |
| SN 2.5 | Rotavirus antigen | Whole blood/serum/plasma | 30 tests/box | 18 months | >99% | 99% | |
| SN 2.6 | Combo Adeno+Rotavirus Ag. | Whole blood/serum/plasma | 30 tests/box | 18 months | >99% | 99% |
OEM and bulk packaging are available for all products
If you have any questions or wish to order this product please click here
 Tumor Markers rapid tests
Tumor Markers rapid tests
IVD for professional use
| Code | Product / format | specimen | package | Shelf life | Sensitivity | Specificity | Inserts |
| SN3.1 | AFP strip | Serum/plasma | 50 tests/box | 18 months | 25 ng/mL | 99% | |
| SN3.2 | AFP cassette | Serum/plasma | 30 tests/box | 18 months | 25 ng/mL | 99% | |
| SN3.3 | CEA strip | Serum/plasma | 50 tests/box | 18 months | 5 ng/mL | 99% | |
| SN3.4 | CEA cassette | Serum/plasma | 30 tests/box | 18 months | 5 ng/mL | 99% | |
| SN3.5 | PSA strip | Serum/plasma/Whole blood | 50 tests/box | 18 months | 4 ng/mL | 98% | |
| SN3.6 | PSA cassette | Serum/plasma/Whole blood | 30 tests/box | 18 months | 4 ng/mL | 98% | |
| SN3.7 | FOB cassette | Feces | 30 tests/box | 18 months | 50 ng/mL | 98% |
OEM and bulk packaging are available for all products
If you have any questions or wish to order this product please click here
 Sexually transmited diseases rapid tests
Sexually transmited diseases rapid tests
IVD for professional use
| Code | Product / format | specimen | package | Shelf life | Sensitivity | Specificity | Inserts |
| SN4.1 | Syphilis strip | Serum/plasma/ Whole blood | 50 tests/box | 18 months | >99% | 99% | |
| SN4.2 | Syphilis cassette | Whole blood/serum/plasma | 30 tests/box | 18 months | >99% | 99% | |
| SN4.3 | Gonorrhea strip | Vaginal/Urethral swabs | 50 tests/box | 18 months | 108bacterial / mL | >99% | |
| SN4.4 | Gonorrhea cassette | Vaginal/Urethral swabs | 30 tests/box | 18 months | 1X108CFU/ mL | >99% | |
| SN4.5 | Chlamydia cassette | Vaginal/Urethral swabs | 30 tests/box | 18 months | 5X108CFU / mL | 97% |
OEM and bulk packaging are available for all products
If you have any questions or wish to order this product please click here
 Hepatitis rapid tests
Hepatitis rapid tests
IVD for professional use
| Code | Product / format | specimen | package | Shelf life | Sensitivity | Specificity | Inserts |
| SN5.1 | HBsAg strip | Serum/plasma/ Whole blood | 50 tests/box | 24 months | 1ng/mL | >98% | |
| SN5.2 | HBsAg cassette | Serum/plasma/ Whole blood | 30 tests/box | 24 months | 1ng/mL | >98% | |
| SN5.3 | Anti-HCV strip | Serum/plasma/ Whole blood | 50 tests/box | 18 months | >99% | 99,5% | |
| SN5.4 | Anti-HCV cassette | Serum/plasma/ Whole blood | 30 tests/box | 18 months | 99,9% | 99,5% | |
| SN5.5 | Anti-HBs strip | Serum/plasma/whole blood | 50 tests/box | 18 months | 20 mIU/mL | 99% | |
| SN5.6 | Anti-HBs cassette | Serum/plasma/whole blood | 30 tests/box | 18 months | 20 mIU/mL | 99% | |
| SN5.7 | Anti-HBc strip | Serum/plasma/whole blood | 50 tests/box | 18 months | >99% | 99% | |
| SN5.8 | Anti-HBc cassette | Serum/plasma/whole blood | 30 tests/box | 18 months | >99% | 99% | |
| SN5.9 | Anti-HBe strip | Serum/plasma/whole blood | 50 tests/box | 18 months | |||
| SN5.10 | Anti-HBe cassette | Serum/plasma/whole blood | 30 tests/box | 18 months | |||
| SN5.11 | HBeAg strip | Serum/plasma/whole blood | 50 tests/box | 18 months | |||
| SN5.12 | HBeAg cassette | Serum/plasma/whole blood | 30 tests/box | 18 months | |||
| SN5.13 | Anti-HAV IgG/IgM cassette | Serum/plasma/Whole blood | 30 tests/box | 18 months | |||
| SN5.X.3 | 3 tests- infectious panel | Serum/plasma/Whole blood | 30 tests/box | 18 months | 99% |
OEM and bulk packaging are available for all products
If you have any questions or wish to order this product please click here
 Cardiac Markers rapid tests
Cardiac Markers rapid tests
IVD for professional use
| Code | Product / format | specimen | package | Shelf life | Sensitivity | Specificity | Inserts |
| SN6.1 | Troponin I cassette | Whole blood/serum/plasma | 30 tests/box | 18 months | 0,5 ng/mL | 98% | |
| SN6.2 | Myoglobin cassette | Whole blood/serum/plasma | 30 tests/box | 18 months | 50 ng/mL | 99% | |
| SN6.3 | CK-MB | Whole blood/serum/plasma | 30 tests/box | 18 months | 7 ng/mL | 99% | |
| SN6.X.3 | panel cTnI+CKMB+Myo | Whole blood/serum/plasma | 30 tests/box | 18 months |
OEM and bulk packaging are available for all products
If you have any questions or wish to order this product please click here
 Drugs of Abuse rapid tests
Drugs of Abuse rapid tests
IVD for professional use
SN 7.14| Code | Product / format | specimen | package | Shelf life | Sensitivity | Specificity | Inserts |
| SN7.1 | AMP strip/cassette | urine/saliva | 50/30 tests/box | 18 months | 1000 ng/mL / 50ng/mL | 97,5% | |
| SN7.2 | BAR strip/cassette | urine | 50/30 tests/box | 18 months | 300 ng/mL | 97,5% | |
| SN7.3 | BZO strip/cassette | urine | 50/30 tests/box | 18 months | 300 ng/mL | 95% | |
| SN7.4 | COC strip/cassette | urine/saliva | 50/30 tests/box | 18 months | 300 ng/mL / 30ng/mL | 97,5% | |
| SN7.5 | MDMA strip/cassette | urine/saliva | 50/30 tests/box | 18 months | 500 ng/mL / 50ng/mL | 99% | |
| SN7.6 | MET strip/cassette | urine/saliva | 50/30 tests/box | 18 months | 1000 ng/mL / 50 ng/mL | 97,5% | |
| SN7.7 | MOR strip/cassette | urine | 50/30 tests/box | 18 months | 300 ng/mL | 99% | |
| SN7.8 | MTD strip/cassette | urine | 50/30 tests/box | 18 months | 300 ng/mL | 97,5% | |
| SN7.9 | OPI strip/cassette | urine/saliva | 50/30 tests/box | 18 months | 2000 ng/mL / 40ng/mL | 95% | |
| SN7.10 | TCA strip/cassette | urine | 50/30 tests/box | 18 months | 1000 ng/mL | 93% | |
| SN7.11 | THC strip/cassette | urine/saliva | 50/30 tests/box | 18 months | 50 ng/mL / 25ng/mL | >99% | |
| SN 7.14 | OXY strip/cassette | urine/saliva | 50/30 tests/box | 18 months | 100 ng/mL / 50ng/mL | 95% | |
| SN 7.X.X | Multi DOA panel | urine | 30 tests/box | 18 months | NA | NA |
OEM and bulk packaging are available for all products
If you have any questions or wish to order this product please click here
 Parasitology rapid tests
Parasitology rapid tests
IVD for professional use
| Code | Product / format | specimen | package | Shelf life | Sensitivity | Specificity | Inserts |
| SN 8.1 | Malaria cassette | Whole blood | 30 tests/box | 24 months | >99% | >99% | |
| SN 8.1' | Malaria pf/pv Ag. cassette | Whole blood | 30 tests/box | 24 months | >99% | >99% | |
| SN 8.2 | Dengue IgG/IgM Ab. cassette | Whole blood/serum/plasma | 30 tests/box | 24 months | 95,7% | 99,9 | |
| SN 8.3 | Dengue NS1 Ag. cassette | Whole blood/serum/plasma | 30 tests/box | 24 months | 96,1% | 98,7% | |
| SN 8.4 | Dengue Combo cassette | Whole blood/serum/plasma | 30 tests/box | 24 months | |||
| SN 8.5 | Coronavirus Ab. cassette | Whole blood/serum/plasma | 30 tests/box | 18 months | 90% | 99% | |
| SN 8.6 | Influenza A+B Ag. cassette | nasopharyngeal secretions | 30 tests/box | 24 months | 90% | 95% | |
| SN 8.7 | Coronavirus Ag. cassette | nasopharingeal secretions | 25 tests/box | 18-24 months | 93,75% | 98,04% | |
| SN 8.8 | DUO PANEL | nasopharyngeal secretions | 25 tests/box | 24 months | % | % |
OEM and bulk packaging are available for all products
If you have any questions or wish to order this product please click here
Microbiology rapid tests
Microbiology rapid tests
IVD for professional use
| Code | Product / format | specimen | package | Shelf life | Sensitivity | Specificity | Inserts |
| SN 9.1 | Tuberculosis cassette | Whole blood/serum/plasma | 30 tests/box | 24 months | |||
| SN 9.2 | Salmonella (Typhoid fever) cassette | Whole blood/serum/plasma | 30 tests/box | 24 months |
OEM and bulk packaging are available for all products
If you have any questions or wish to order this product please click here
 TORCH
TORCH
IVD for professional use
| Code | Product / format | specimen | package | Shelf life | Sensitivity | Specificity | Inserts |
| SN 10.1 | Rubella IgG/IgM cassette | Whole blood/serum/plasma | 30 tests/box | 24 months | 97% / 98% | 99% | |
| SN 10.2 | Toxoplasma IgG/IgM cassette | Whole blood/serum/plasma | 30 tests/box | 24 months | 96% / 98% | 99% | |
| SN 10.3 | Cytomegalovirus IgG/IgM cassette | Whole blood/serum/plasma | 30 tests/box | 24 months | 96% / 97% | 99% | |
| SN 10.4 | Herpes Simples IgG/IgM cassette | Whole blood/serum/plasma | 30 tests/box | 24 months | 96% / 98% | 99% |
OEM and bulk packaging are available for all products
If you have any questions or wish to order this product please click here
 Bacteriology rapid tests
Bacteriology rapid tests
IVD for professional use
| Code | Product / format | specimen | package | Shelf life | Sensitivity | Specificity | Inserts |
| SN 11.1 | Tetanus cassette | Whole blood | 30 tests/box | 24 months | |||
| SN 11.2 | Streptococ A antigen | Whole blood | 30 tests/box | 24 months |
OEM and bulk packaging are available for all products
If you have any questions or wish to order this product please click here
 Toxicology rapid tests
Toxicology rapid tests
IVD for professional use
| Code | Product / format | specimen | package | Shelf life | Sensitivity | Specificity | Inserts |
| SN 12.1 | Alcohol strip | Urine / saliva | 50 tests/box | 24 months |
OEM and bulk packaging are available for all products
If you have any questions or wish to order this product please click here
 Urine rapid tests
Urine rapid tests
IVD for professional use
| Code | Product / format | specimen | package | Shelf life | Sensitivity | Specificity | Inserts |
| SN 13.1 | Urine strips - 10 para | urine | 100 tests/box | 24 months | |||
| SN 13.2 | Urine strips - 11 para | urine | 100 tests/box | 24 months | |||
| SN 13.3 | Urine strips - 12 para | urine | 100 tests/box | 24 months | |||
| SN 13.4 | Urine strips - 13 para | urine | 100 tests/box | 24 months |
OEM and bulk packaging are available for all products
If you have any questions or wish to order this product please click here










